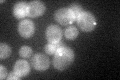
YNL212W
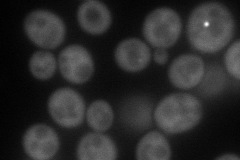
YNL212W
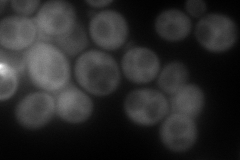
YNL212W
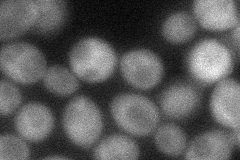
YNL212W
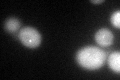
YNL212W
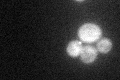
YNL212W
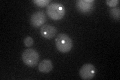
YNL212W

View description
Cytoplasmic protein of unknown function; possibly involved in vacuolar protein degradation; not essential for proteasome-dependent degradation of fructose-1,6-bisphosphatase (FBPase); null mutants exhibit normal growth
Localization:
Intensity:
Fold change:
Significance:
-
C’ GFP library in SD
cytosol37.17 -
N' NOP1pr-GFP in SD
cytosol,punctate133.889 -
N' TEF2pr-mCherry in SD
cytosol181.697 -
N' NATIVEpr-GFP in SD

punctate32.1656 -
N' TEF2pr-VC and Cyto-VN in SD
cytosol61.6595 -
C’ GFP library in SD+DTT
cytosol40.891.09No -
C’ GFP library in SD+H2O2
cytosol40.771.09No -
C’ GFP library in Starvation Media
cytosol58.181.56Yes -
C’ GFP library on the background of Pup2-DaMP

cytosol -
C’ GFP library on the background of CCT mutant

cytosol33.11860.890723No
